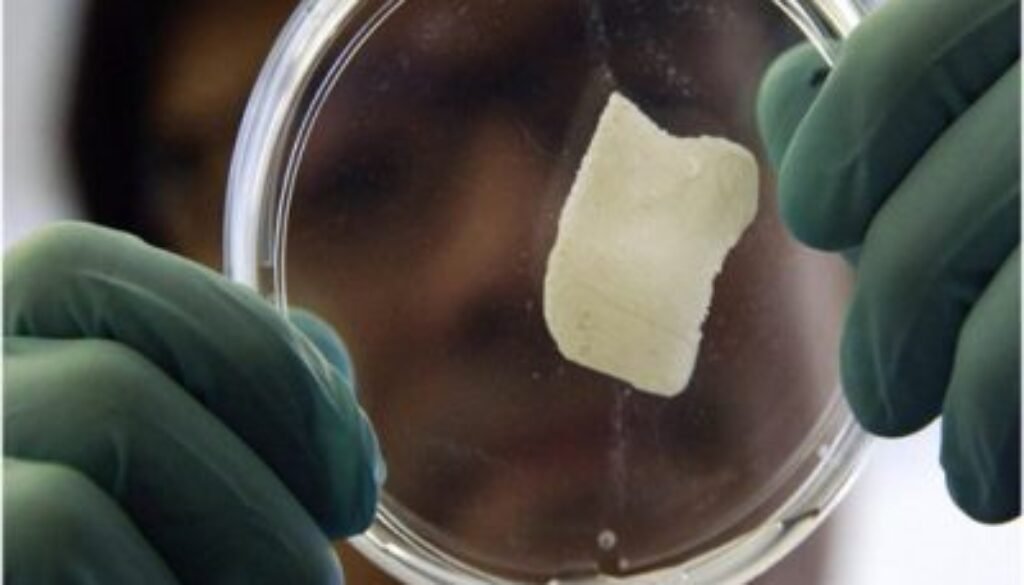
Living-Bones

کولمبیا میں پہلی بار زندہ ہڈیاں اگانے کا کامیاب تجربہ
وہ دن دور نہیں جب متاثرہ افراد کی ٹوٹی ہڈیاں ان ہی کے جسم سے خلیات لے کر تجربہ گاہ میں تیار کرلی جائیں گی کیونکہ کولمبیا یونیورسٹی کے ماہرین کی سربراہی میں ایک ریسرچ ٹیم نے پہلی بار تجربہ گاہ میں زندہ ہڈیاں اگالی ہیں ، اگرچہ یہ تجربہ ایک سور پر کیا گیا لیکن سائنسدانوں کو امید ہے کہ یہی عمل انسانوں میں بھی کامیابی سے کیا جاسکے گا۔تجربہ گاہ میں زندہ ہڈیاں اگانے کیلئے سور کے جسم سے چربی کے خلیات لئے گئے اور انہیں ‘سٹیم سیلز’ میں تبدیل کردیا گیا ۔ اس کے ساتھ ہی ہڈی کی مطلوبہ ساخت والا ایک مچان تیار کیا گیا۔ان خلیاتِ ساق اور مچان کو ایک عدد بائیو ری ایکٹر میں پہنچادیا گیا ۔ ماہرین کے مطابق اگلے 3 ہفتوں کے دوران خلیاتِ ساق نے خود کو تبدیل کیا اور مچان کی ساخت کے مطابق یہ ایسی ہڈی میں تبدیل ہوگئے جس کے اندر خون کی نالیاں بھی موجود تھیں۔کسی بھی ہڈی کے زندہ رہنے اور نشوونما پانے کیلئے اس میں خون کی نالیوں کا موجود ہونا اشد ضروری ہوتا ہے ۔ بعد ازاں یہ ہڈی واپس سور کے جسم میں پیوند کردی گئی جہاں اس نے کامیابی سے اپنی ٹوٹی ہڈی کی جگہ لے لی۔